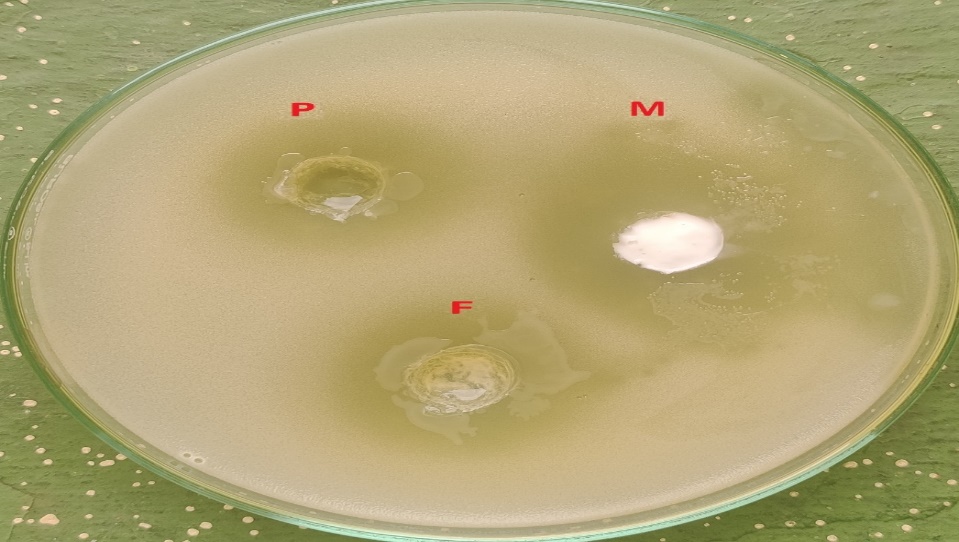

1College of Pharmaceutical Sciences, Govt. Medical College, Kozhikode 673008, India
*Email: subair007.tk@gmail.com
Received: 04 Sep 2021, Revised and Accepted: 09 Dec 2021
ABSTRACT
Objective: Luliconazole (LZL) has low aqueous solubility that limits its dermal bioavailability and acts as a barrier to topical delivery. The conventional topical formulations have a limited ability to retain the drug over the skin for a prolonged period. The main objective of the study was to formulate and characterize LZL loaded ethyl cellulose (EC) nanoparticles and formulate them as a film-forming gel (FFG) for prolonged delivery in fungal skin infections.
Methods: The solvent evaporation technique was used for the preparation of nanoparticles of LZL by using EC as a polymer. The prepared nanoparticles were evaluated for physical appearance, production yield, entrapment efficiency, drug content, particle size, zeta potential, Polydispersity index (PDI), and in vitro drug release. Then the nanoparticles were incorporated into FFG formulation by using polyvinyl pyrrolidone (PVP) and polyvinyl alcohol (PVA) as the gelling agent. The prepared FFG was evaluated for pH, Viscosity, Spreadability, in vitro drug release studies, in vitro antifungal studies, and release kinetic studies.
Results: The optimized nanoparticle formulation F5 having drug to polymer ratio of 1:2 showed satisfactory production yield (86.32%), entrapment efficiency (83.36%), drug content (42.86), particle size (125.3), and 93.72% of in vitro drug release after 24 h (h). The optimized FFG formulation FFG4 showed the shortest film-forming time of 5.06 min (min), percentage Cumulative drug release of 92.18% after 24 h, and had promising in vitro antifungal activity.
Conclusion: The prepared FFG could be used with promising potential for fungal infection of the skin.
Keywords: Film-forming gel, Nanoparticle, Solvent evaporation method, Luliconazole, Ethylcellulose, Polyvinyl pyrrolidone, Polyvinyl alcohol
© 2022 The Authors. Published by Innovare Academic Sciences Pvt Ltd. This is an open access article under the CC BY license (https://creativecommons.org/licenses/by/4.0/)
DOI: https://dx.doi.org/10.22159/ijpps.2022v14i2.43253. Journal homepage: https://innovareacademics.in/journals/index.php/ijpps.
LZL is a topical broad-spectrum antifungal drug approved by the US-FDA in November 2013. It has lower aqueous solubility that limits dermal bioavailability and acts as a barrier to topical delivery [1]. The solubility of the drug in the lipid phase of the stratum corneum also acts as a rate-limiting step for permeation. Fungal infection involves the epidermis, dermis as well as deeper layers of skin that require to customize the drug delivery in such a way that localizes high drug concentrations at the epidermis and dermis layer [2]. The topical route offers a large and varied surface in addition to the ease of application via self-administration and provides an alternative to oral delivery of drugs as well as hypodermic injection. The rate and extent of drug absorption through the skin depends on the skin physiology and physicochemical properties of drugs as well as the delivery system. The current dosage forms are associated with several limitations such as skin irritation, do not ensure persistent contact with the skin surface, and can be easily wiped off by the patient's clothes; repeated application is required. Also, these leave a sticky and greasy feel after application leading to poor patient compliance [3].
Presently nanoparticles have gained increasing interest and are found to be superior to other nano-particulate systems due to high drug payload capacity, use of the minute quantity of excipients, higher chemical stability, lower toxicity, easy scale-up, and manufacturing [4]. Incorporation of this nanoparticle system into an FFG formulation would facilitate prolonged contact of the drug on the skin and the film formed on drying would improve its skin retention ability, thereby prolonging the delivery of antifungal drugs. The FFG system contains the drug and film-forming excipients in a vehicle which, upon contact with the skin, leaves behind a film of excipients along with the drug upon solvent evaporation. The formed film can either be a solid polymeric material that acts as a matrix for sustained release of drugs to the skin [5]. Thus, the study aimed to develop a nanoparticle system of LZL by using EC and formulate them into an FFG by using PVP and PVA to improve the topical treatment of fungal skin infections.
Luliconazole was purchased from Yarrow Chem Labs, Mumbai, Ethylcellulose from Sigma Aldrich, Bangalore, Polyvinyl pyrrolidone from Sigma Aldrich, Bangalore, Polyvinyl alcohol from Oxford Laboratory, Mumbai. All the chemicals were in analytical grade.
Preparation of LZL nanoparticles
The nanoparticles were prepared by solvent evaporation technique. Biocompatible polymer EC was used for the formulation of nanoparticles. Dichloromethane (DCM) was used as a solvent for polymers and drugs (organic phase). PVA in 0.5% concentration was used as the stabilizing agent (aqueous phase). An accurately weighed the required quantities of LZL and EC as per table 1 and dissolved in 10 ml of dichloromethane (DCM). The solution was then added to 90 ml of 0.5% PVA solution and kept in an ultrasonicator for 15 min. It was stirred with a magnetic stirrer at 1500 rpm for 4 h. The temperature was maintained at 40 ℃ for the evaporation of residual DCM. The dispersion was then centrifuged in a cold centrifuge at 9000 rpm for 20 min. The supernatant was removed and the nanoparticles were collected and dried at room temperature for 12 h [6, 7].
Evaluation of LZL loaded EC nanoparticles
Physical appearance
Organoleptic properties were observed
Percentage yield (PY)
The weight of nanoparticles was measured and the percentage yield was determined by using the formula [8].

Table 1: Composition of luliconazole nanoparticles
| Formulation code | Drug: polymer ratio | Drug (mg) | EC (mg) | DCM (ml) | PVA (0.5%) (ml) |
| F1 | 1:10 | 100 | 1000 | 10 | 90 |
| F2 | 1:5 | 100 | 500 | 10 | 90 |
| F3 | 1:4 | 100 | 400 | 10 | 90 |
| F4 | 1:3 | 100 | 300 | 10 | 90 |
| F5 | 1:2 | 100 | 200 | 10 | 90 |
| F6 | 1:1 | 100 | 100 | 10 | 90 |
Entrapment efficiency (EE) and drug content (DC)
Accurately weighed 10 mg of nanoparticles and dissolved in a minimum amount of methanol by crushing the nanoparticles in a mortar and pestle. The solution was transferred into a volumetric flask and made up to a volume of 100 ml with phosphate buffer pH 7.4. It was filtered using a 0.45 μm syringe filter. The LZL content was analyzed at 300.5 nm spectrophotometrically after suitable dilutions. Entrapment efficiency was determined by using the formula [8].


Particle size, polydispersity index, and zeta potential
Particle size, polydispersity index, and zeta potential were measured by dynamic laser scattering or photon correlation spectroscopy using a Malvern zeta sizer Nano ZS (Malvern Instruments, Malvern, UK), 1-3 mg of nanoparticles were suspended in double distilled water, then vortexed and/or sonicated for few min and measured at 25 °C and a scattering angle of 90°. To determine the zeta potential, nanoparticles were dispersed in deionized water and taken in a disposable zeta cell and measured by Malvern zeta sizer. Each sample was measured in triplicate [9].
In vitro drug release study
LZL loaded nanoparticles were characterized for in vitro drug release test as specified in USP dissolution apparatus 2 (SOTAX, AT7 smart). An accurately weighed amount of nanoparticles equivalent to 50 mg of LZL was positioned in a clean muslin cloth previously washed with distilled water and kept soaked in phosphate buffer pH 7.4. This bag was then attached to the paddle and suspended into 900 ml of phosphate buffer pH 7.4 used as dissolution medium at a paddle rotation speed of 50 rotations per min (rpm). Samples from the dissolution medium were withdrawn at predetermined intervals and LZL content was spectrophotometrically determined at 300.5 nm. The experiment was carried out for a period of 24 h. Cumulative percentage drug release versus time graph was plotted [9].
Evaluation of optimized formulation F5
Differential scanning calorimetry (DSC)
The physical state of the drug entrapped in the nanoparticles was characterized by DSC (DSC Q200-V24.11 Build 124), equipped with an automated computer-controlled refrigerated cooling system.
A sample of 5-10 mg of drug and nanoparticle formulation was placed in a standard aluminium pan with a lid. The heating rate was set to 10 °C/min between 30-300 °C. Measured DSC data were analyzed using a coupled DSC Q200 data station and compared with pure drugs [10].
Infrared (IR) spectroscopy of the nanoparticles
The IR spectrum of the optimized nanoparticles was taken and compared with that of the IR spectrum of the pure drug by the peak matching method (Bruker alpha-E-, Zn Se ATR). The mixture was placed on the crystal surface of the Attenuated total reflectance (ATR) attachment. Gently press down on the anvil till it makes contact with the sample. The anvil arm was rotated to ensure full contact is made with the crystal. The spectrum was scanned in the wavelength range of 400-4000 cm-1 and the intensity quotient of transmitted light to the incident light was measured [3].
Formulation of FFG containing LZL loaded EC nanoparticles
The FFG was prepared by using a polymer of PVA and PVP as a gelling agent. Glycerol was used as a plasticizer and distilled water as a solvent. An accurately weighed amounts of PVA and PVP in different ratios as per table 2 were mixed and dissolved in water by heating on a water bath with continuous stirring until a homogenous mixture was formed, to which 3% v/v of glycerol was added under continuous stirring by magnetic stirrer for 1 h and the volume was made up to 100 ml with distilled water. The predetermined quantity of nanoparticles was dispersed slowly under magnetic stirring at 250 rpm for 6 h at ambient temperature to ensure that all of the nanoparticles were dispersed in the gel [11, 12].
Evaluation of FFG
Determination of pH
The pH of the formulation was determined by using a digital pH meter (Hitachi SU6600, FESE). The measurement of pH was carried out in triplicate [3, 6].
Viscosity
The viscosity of different formulations was determined by repeated trial and error method using Brook field viscometer (RVDVE, spindle S21) with spindle number 21 at various rpm ranging from 50 to 100. The viscosity values were measured at room temperature (25 ℃) [13].
Table 2: Composition of film-forming gel
| Formulation code | Total polymer concentration w/v | PVA: PVP ratio | Glycerol v/v |
| FFG1 | 12% | 10:2 | 3% |
| FFG2 | 12% | 10:4 | 3% |
| FFG3 | 10% | 10:2 | 3% |
| FFG4 | 10% | 10:4 | 3% |
| FFG5 | 10% | 10:2 | 5% |
| FFG6 | 12% | 10:4 | 5% |
Spreadability
The spreadability of the formulation was determined by measuring the spreading diameter of 0.5 g of gel formulation placed between two horizontal smooth surface glass plates (20 cm × 20 cm). The initial diameter in centimeters formed by placing the gel on the glass plate was noted. Another glass plate (weighing 200 g) with the same dimensions was placed over the gel for 1 min until no more expansion of the gel was observed. The upper plate was gradually removed and the diameter of the circle formed after spreading of the gel was measured in centimeters [14].
Film-forming time
1 g of gel was placed on a Petri dish which was spread uniformly on it and kept on a hot plate at 37˚C and the time needed until gel converts into film was measured [15].
Folding endurance
A strip of film was taken from the above petri dish with dimension 2 cm x 2 cm and folding endurance was measured manually by repeatedly folding the film at the same place till it broke or was folded up to 200 times without breaking. The number of times the film could be folded at the same place without breaking was the folding endurance value [2].
In vitro drug release of nanoparticle loaded FFG
The in vitro drug release studies were carried out using a dialysis bag made of cellophane membrane (HIMEDIA LA390-5MT, 60). The dialysis bag was prepared by immersing it in phosphate buffer pH 7.4 for 12 h for proper wetting, followed by tying at one end. 0.3 g of gel containing nanoparticles equivalent to 1 % of LZL was added to the dialysis bag followed by tying the other end. It was then immersed in 50 ml of phosphate buffer pH 7.4 maintained at 37±0.5 ℃. The receptor chamber was rotated at 300 rpm with the aid of a magnetic stirrer. 5 ml of sample was withdrawn at every 1 h and replaced with an equal volume of phosphate buffer pH 7.4. It was then filtered and the LZL content was measured at 300.5 nm by using a UV spectrophotometer after suitable dilutions [9].
Evaluation of optimized FFG FFG4
Scanning electron microscopy (SEM)
The morphology of the optimized nanoparticles loaded FFG was characterized by using a scanning electron microscope (Hitachi SU6600, FESEM). For liquid samples, a piece of aluminium foil was spread over a glass plate and a drop of the sample was placed on to the center of the foil, which was then air-dried overnight. The sample was coated with gold and examined under the electron microscope [13].
Comparison of In vitro drug release with marketed formulation
The in vitro drug release of the marketed formulation (Lulifin, 1% w/v) was carried out and compared with the optimized gel formulation.
In vitro antifungal activity
Microorganism used
Candida albicans, MTCC 1637 was obtained from Microbiology laboratory of the College of Pharmaceutical Sciences, Govt. Medical College, Kozhikode.
Preparation and sterilization of media
Weighed 16.25 g of Sabouraud dextrose agar was transferred in 500 ml of the conical flask and 250 ml of purified water and some amount of heat is applied to dissolve it completely. Sterilized at 121 °C at 15 lbs pressure in an autoclave for about 15 min. Then cooled it at room temperature.
Method
The fungal strain was dispersed in the medium and then the medium was poured into the Petri dish and allowed it cool for some time at room temperature until it forms solidifies and then the cup was bored in the Petri dish with the help of a sterile steel borer of 6 mm and calculated amount of the marketed formulation (M) (Lulifin, 1% w/v), optimized FFG (F) and pure drug (P) were placed in the bores and incubated the Petri plates for 24 h at 37 °C in incubators. Then the zone of inhibition was observed and calculated the diameter of the zone of inhibition. All the operations were done aseptically [9, 13].
In vitro drug release kinetic study
To examine the drug release kinetics and to evaluate the release mechanism of the drug, the results of in vitro drug release profiles obtained for the optimized formulation FFG4 were fitted into zero-order, first-order, Higuchi, and Korsmeyer-Peppas models. The model with the highest regression coefficient (R2) was considered to be the best fit model [16, 17].
Preparation of LZL nanoparticles
LZL nanoparticles were prepared by a solvent evaporation method. The stirring was carried out at 1500 rpm to obtain small uniform-sized particles with maximum drug entrapment. Ultrasonication was done to reduce the particles to the nanometer size range. Nanoparticles were prepared using EC to retard the drug release. The concentration of the aqueous phase was optimized to obtain nanoparticles with maximum percentage drug entrapment. There was no significant difference in percentage drug entrapment with PVA concentration 0.3–0.5% (w/v). Therefore 0.5% (w/v) PVA was recorded as optimized aqueous phase concentration. Ultracentrifugation was used for the formation of nanoparticles and the removal of the unentrapped drug. The nanoparticles were obtained for all the formulations.
Evaluation of nanoparticles
Physical appearance
The physical appearances of the prepared nanoparticles were observed visually. All batches observed were white, odorless powder.
Percentage yield
The percentage yields of the formulations were shown in table 3. The percentage yield was found to be in the range of 73.78-86.32%. The F1 and F5 batches showed good percentage yields (90.45% and 86.32%). It concluded that Ethylcellulose concentration may affect the percentage yield of nanoparticles [6].
Entrapment efficiency and drug content
The results of the entrapment efficiency of the formulations were found to be in the range of 47.32%-83.36% (table 3, fig. 1); entrapment efficiency was increased from F1 (1:10) to F5 (1:2) with decreasing polymer concentration. F6 showed a decreased value of entrapment efficiency due to insufficient polymer concentration [9].

Fig. 1: Entrapment efficiency of luliconazole nanoparticles, *(mean±SD) n = 3
The drug contents of all the formulations were found to be in the range of 8.26%-42.86% (table 3). Drug content was increased from F1 (1:10) to F5 (1:2) with decreasing the polymer concentration [9].
Particle size, Polydispersity index, and zeta potential
Particle size, PDI, and zeta potential of prepared nanoparticles were analyzed and shown in table 4, fig. 2, and fig. 3. Particle size and zeta potential were the most important parameter for the stability of nanoparticles.
Average particle sizes were in the range of 125-559 nm. The small particle size of the formulated system confirmed the applicability of the formulation for administration through topical route, thus improving permeability through the skin and also dermal availability of poorly soluble drug LZL was enhanced. PDI was found to be in the range of 0.093 to 0.478. Low poly dispersibility index (<0.5) obtained confirms the narrow distribution of the formulation and hence indicates monodisperse system and therefore has less tendency to aggregate. Greater positive or greater negative values of zeta potential result in stronger repulsive forces; also, particles with similar charges causes repulsion and hence maintain the stability of the formulation. It was noticed that zeta potential values of the formulated nanoparticles drug were in the desirable range of–8.5 to-25.5 mV [13].



Fig. 2: Particle size and polydispersity index of the formulations F1–F6
Table 3: Evaluation of nanoparticles
| Formulation code | Percentage yield (%) | Percentage drug content (%) | % Entrapment efficiency |
| F1 | 90.45±0.63 | 8.26±0.32 | 47.32±0.12 |
| F2 | 73.78±0.07 | 18.21±0.25 | 63.81±0.04 |
| F3 | 80.74±0.43 | 22.70±0.43 | 71.12±0.07 |
| F4 | 78.21±0.56 | 31.11±0.28 | 76.33±0.13 |
| F5 | 86.32±0.13 | 42.86±0.16 | 83.36±0.03 |
| F6 | 79.55±0.41 | 35.58±0.67 | 78.41±0.08 |
*(n =3, mean±standard deviation (SD))



Fig. 3: Zeta potential of formulations F1-F6
Table 4: Particle size, polydispersity index, and zeta potential
| Formulation code | Particle size (nm) | Zeta potential (mV) | Polydispersity index |
| F1 | 395.4 | -8.57 | 0.463 |
| F2 | 265.6 | -18.2 | 0.360 |
| F3 | 311.4 | -9.6 | 0.363 |
| F4 | 558.3 | -12.7 | 0.093 |
| F5 | 125.3 | -25.5 | 0.193 |
| F6 | 363.7 | -15.3 | 0.478 |
In vitro drug release study

Fig. 4: Percentage cumulative drug release of nanoparticles formulations F1-F6
The drug release characteristics of the nanoparticle formulations were carried out by using USP type 2 apparatus in phosphate buffer pH 7.4 for the formulations F1 toF6 (fig. 4). The formulation F1 showed a very low % cumulative drug release after 24 h (23.14%) due to the high concentration of polymer. Of the six formulations, the maximum release was found to be for formulation F5 after 24 h (93.72%). As the polymer ratio varies, the drug release also varies. Formulation F5 showed sustained release up to 24 h [7].
Evaluation of optimized nanoparticle formulation F5
Differential scanning calorimetry
The DSC thermograms of pure drugs and the nanoparticle formulation are shown in fig. 5 and 6.
The DSC thermogram of the pure drug (fig. 5) showed a sharp melting point at 151.48 ℃. The optimized nanoparticle formulation was subjected to DSC analysis. The results were shown in fig. 6. The DSC thermogram of the optimized formulation showed a sharp peak at 152.57 ℃, which was broader than the DSC of pure drugs and there was no significant change in the melting point. It concludes that the characteristic of the drug was not lost after the formulation of nanoparticles. It also suggested the absence of any drug-polymer interactions, which might have resulted in the degradation of the drug [9].
IR spectrum analysis of the nanoparticles
The IR spectrum analysis of the nanoparticles (fig. 7) was carried out and was compared with the IR spectrum of the pure drug (fig. 8).

Fig. 5: Differential scanning calorimetry thermogram of luliconazole (pure drug)

Fig. 6: Differential scanning calorimetry thermogram of optimized luliconazole nanoparticles (F5)

Fig. 7: Infrared spectrum of optimized nanoparticles

Fig. 8: Infrared spectrum of the pure drug (Luliconazole)
Table 5: Infrared spectroscopic peaks obtained in pure drug and nanoparticles
| Pure drug (Cm-1) | Nanoparticles (Cm-1) | Characterization |
| 3039, 3119, 3076 | 3045 | C-H Aromatic stretch |
| 2527, 2614 | 2590 | S-H Stretch |
| 1634 | 1650 | C=N stretch |
The spectrum obtained from the nanoparticles of LZL was compared with that of the pure drug (table 5). The majority of peaks present in the spectrum of the pure drug were observed in the spectrum of nanoparticles without change in position. This indicated that the drug (LZL) is well preserved in the nanoparticles. Also, some of the characteristic peaks of pure drug LZL were absent in the spectrum of optimized nanoparticle formulation indicated that the drug has been entrapped within the formulation [1].
Formulation of FFG containing LZL loaded EC nanoparticles
LZL loaded nanoparticle FFG was formulated using polymers (PVP and PVA). The prepared formulations showed good homogeneity with the absence of lumps and were transparent.
Evaluation of FFG
Determination of pH
The pH of all the FFG was found to be in the range of 6.02-6.93 (table 6), which was in the acceptable pH range. The pH of the transdermal formulation should be in the range of 5-9. The obtained pH was close to the pH of the skin and was considered satisfactory for application with minimal risk of tissue irritation [15].
Viscosity
The viscosity was found to be in the range of 4028-5233 cps for the formulations FFG1-FFG6 (table 6). The viscosity was increased with increasing the polymer concentration and the viscosity was decreased by increasing the concentration of PVP [11].
Spreadability
The spreading diameters of FFG were found to be in the range of 5.2 to 7.3 cm (table 6). This indicates that the spreadability was increased with a decrease in polymer concentration and an increase in glycerol concentration [14].
Film-forming time
The film-forming time of gel was observed as shown in table 6. To investigate the effect of polymer concentration on the FFG, various formulations were prepared with total polymer concentrations of 10% and 12% (PVA/PVP) using 3% glycerol as plasticizer (formulations FFG1-FFG4). Film-forming time in these formulations ranged from 6 min 28 s±5 s to 5 min 06 s±5 s; Variation in ratio of PVA: PVP polymeric blend resulted in different film-forming time: Higher drying time being observed with formulations containing higher concentrations of PVA. In the case of using higher concentrations of the plasticizer glycerol, the drying time was increased from 5 min 06 s±5 s to 8 min 12 s±5 s in a formulation containing 3% and 5% of glycerol [11].
Folding endurance
The folding endurance test showed that the films did not show any cracks even after folding more than 200 times (table 6). Such an effect might be attributed to the effect of the glycerol. Folding endurance did not vary among different formulations. This reveals that all films can maintain their integrity and have satisfactory flexibility [15].
Table 6: Evaluation of the Film-forming gel
| Formulation code | pH | Viscosity (cps) | Spreadability (cm) | Film-forming time | Folding endurance |
| FFG1 | 6.49±0.16 | 5233.4±0.73 | 5.8±0.21 | 6 min 28s±5s | >200 |
| FFG2 | 6.93±0.08 | 4802.1±1.6 | 6.2±0.13 | 5 min 32 s±5 s | >200 |
| FFG3 | 6.86±0.04 | 4556.2±1.2 | 6.5±0.32 | 5 min 20 s±5 s | >200 |
| FFG4 | 6.87±0.18 | 4475.6±0.66 | 6.9±0.15 | 5 min 06 s±5 s | >200 |
| FFG5 | 6.02±0.23 | 4028.2±0.47 | 7.7±0.12 | 7 min 42 s±5 s | >200 |
| FFG6 | 6.58±0.06 | 4235.1±0.89 | 7.4±0.20 | 8 min 12 s±5s | >200 |
*(mean±SD) n = 3
In vitro drug release of nanoparticle loaded FFG

Fig. 9: In vitro drug release of nanoparticle loaded Film-forming gel
In vitro drug release profile of LZL from FFG formulation is shown in fig. 9. The % CDR was increased by decreasing the total polymer concentration. Variation in ratio of PVA: PVP polymeric blend produced variation in drug release profile; the percentage drug release was found to be 92.18% after 24 h for PVA: PVP formulations having the ratio of 10:4 when compared to formulations of other ratios. This indicates that as the amount of PVP increased, there was a faster drug release due to the fact PVP, being a hydrophilic polymer dissolves rapidly, introducing porosity, thus increasing solvent diffusion through the gel structure and thereby accelerating the dissolution rate. There was no significant difference observed for the concentration of plasticizer [18].
Evaluation of optimized FFG FFG4
Scanning electron microscopy image of nanoparticle loaded FFG
The shape and surface morphology of the formulation FFG4 were studied by Scanning electron microscopy and are shown in fig. 10. The particles were found to be spherical with nano size.

Fig. 10: SEM image of nanoparticle loaded film-forming gel
Comparison of in vitro drug release with marketed formulation
A comparison of in vitro drug release of optimized formulation FFG4 and the marketed formulation was carried out as shown in fig. 11.

Fig. 11: Comparison of percentage cumulative drug release with marketed formulation
The % CDR of the marketed formulation was higher than the optimized formulation FFG4 after 24 h (96.14%) and after that, there was no significant change. The formulation FFG4 showed 92.18% after 24 h (fig. 11), that the prepared FFG had prolonged drug delivery [6].
In vitro antifungal activity
In vitro antifungal activity results for optimized FFG (F) and marketed formulation (M), and pure drug (P) against fungal strains of Candida albicans were indicated in table 7 and fig. 12. From experimental outcomes, it was concluded that the prepared FFG formulation exhibited promising antifungal activity [8, 13].
Table 7: Observation of in vitro antifungal activity
Sample code |
Zone of inhibition diameter (mm) |
F |
22±0.21 |
M |
36±0.32 |
P |
18±0.16 |
*(mean±SD) n = 3, F: Optimized film-forming gel, M: Marketed formulation (Lulifin 1% w/v), P: Pure drug luliconazole.
In vitro drug release kinetic study
The in vitro drug release data of formulation FFG4 (table 8) was fitted to various kinetic models like zero order, first order, Higuchi model, and Korsmeyer Peppas model. In vitro drug permeation data was subjected to the goodness of fit by linear regression analysis according to zero order, first order, Higuchi, Korsmeyer-Peppas (fig. 13) model to ascertain the mechanism of drug release. The results of linear regression data, including regression coefficient, are listed in table 9.
Fig. 12: In vitro antifungal activity against Candida albicans
Table 8: In vitro drug release kinetics
| S. No. | Time (h) | Log time | Square root of time | % CDR | Log % CDR | Log % CDR remaining |
| 1 | 0 | 0 | 0 | 2.000 | ||
| 2 | 1 | 0 | 1 | 5.96 | 0.7752 | 1.971 |
| 3 | 2 | 0.3010 | 1.414 | 12.91 | 1.110 | 1.931 |
| 4 | 3 | 0.4771 | 1.732 | 20.96 | 1.321 | 1.897 |
| 5 | 4 | 0.6020 | 2 | 27.90 | 1.445 | 1.857 |
| 6 | 5 | 0.6989 | 2.236 | 36.54 | 1.562 | 1.802 |
| 7 | 6 | 0.7781 | 2.449 | 42.83 | 1.631 | 1.757 |
| 8 | 7 | 0.8450 | 2.645 | 48.23 | 1.683 | 1.714 |
| 9 | 8 | 0.9030 | 2.828 | 56.41 | 1.751 | 1.639 |
| 10 | 9 | 0.9542 | 3 | 61.25 | 1.787 | 1.588 |
| 11 | 10 | 1 | 3.162 | 66.47 | 1.822 | 1.525 |
| 12 | 11 | 1.041 | 3.316 | 72.11 | 1.857 | 1.445 |
| 13 | 12 | 1.079 | 3.464 | 75.13 | 1.875 | 1.395 |
| 14 | 24 | 1.380 | 4.898 | 92.18 | 1.964 | 0.895 |

Fig. 13: Release kinetic studies
Table 9: Regression coefficients of various kinetics models
| Zero-order | First-order | Higuchi model | Korsmeyer-peppas model |
| R2 | R2 | R2 | R2 |
| 0.8478 | 0.9919 | 0.9744 | 0.9362 |
The regression coefficient (R2) obtained for first-order kinetics and zero-order kinetics was 0.9919 and 0.8478, respectively. The results indicate that the drug release follows nearing first-order kinetics. The coefficients obtained from the Higuchi model were 0.9744, indicating diffusion played a predominant role in the drug release procedure. The slope obtained from the Korsmeyer-Peppas equation was the ‘n’ value and was found to be 0.8654 indicated that release was by the Non-Fickian transport mechanism. Non-Fickian transport occurs when the drug release is time-dependent and diffusion mechanism [8].
LZL nanoparticles were prepared and incorporated into the FFG successfully. The prepared nanoparticles were evaluated. Based on particle size, zeta potential, PDI, drug content, entrapment efficiency, and in vitro drug release, nanoparticles formulation F5 was selected as an optimized batch. Also, the FFG was prepared and evaluated. Based on the film-forming time, pH, in vitro drug release, formulation FFG4 was selected as the optimized batch. The optimized FFG formulation FFG4 had desired physicochemical properties required for the gel. The in vitro drug release of the optimized batch was compared with the marketed formulation and found that the optimized batch had extended-release. SEM analysis was done for the optimized batch, the particles were found to be spherical in shape and nano size. In vitro Antifungal activity of optimized FFG was evaluated by using Candida albicans by the zone of inhibition method and it was observed that optimized LZL loaded nanoparticle FFG exhibited promising antifungal activity. The optimized formulation showed the highest R2 value for the first-order kinetics with sustained release profile and the ‘n’ value showed a non-Fickian diffusion mechanism. In conclusion, prepared FFG could be used with promising potential for fungal infection.
The authors express their sincere thanks to the College of pharmaceutical sciences, Govt. medical college Kozhikode, Kerala, India for providing the facilities to carry out this research work.
No funding was provided for this study.
All the authors are contributed equally.
The authors declare that they have no conflicts of interest.
Kumar M, Shanthi N, Mahato AK, Soni S, Rajnikanth PS. Preparation of luliconazole nanocrystals loaded hydrogel for improvement of dissolution and antifungal activity. Heliyon. 2019 May 1;5(5):e01688. doi: 10.1016/j.heliyon.2019.e01688, PMID 31193099.
Kyle AA, Dahl MV. Topical therapy for fungal infections. Am J Clin Dermatol. 2004 Dec;5(6):443-51. doi: 10.2165/00128071-200405060-00009, PMID 15663341.
Kathe K, Kathpalia H. Film-forming systems for topical and transdermal drug delivery. Asian J Pharm Sci. 2017 Nov 1;12(6):487-97. doi: 10.1016/j.ajps.2017.07.004, PMID 32104362.
Yadav SA, Poddar SS. Formulation, in vitro and in vivo evaluation of nanoemulsion gel for transdermal drug delivery of nimodipine. Asian J Pharm Clin Res. 2015 Mar 1:119-24.
Attia MA, El Badawy HY. Film-forming gel for the treatment of oral mucositis: in vitro studies. Int J Drug Delivery. 2010 Oct 1;2(4):314-21. doi: 10.5138/ijdd.2010.0975.0215.02043.
Shaikh AN, Pawar AY. Formulation and evaluation of nanosponges loaded hydrogel of luliconazole. Int J Sci Dev Res. 2020;5:215-27.
Saudagar RB. Formulation, development and evaluation of film-forming gel for prolonged dermal delivery of terbinafine hydrochloride. Int J Pharm Sci Res. 2014;5:537-4.
Moin A, Deb TK, Osmani RA, Bhosale RR, Hani U. Fabrication, characterization, and evaluation of microsponge delivery system for facilitated fungal therapy. J Basic Clin Pharm. 2016 Mar;7(2):39-48. doi: 10.4103/0976-0105.177705, PMID 27057125.
Kapileshwari GR, Barve AR, Kumar L, Bhide PJ, Joshi M, Shirodkar RK. Novel drug delivery system of luliconazole- formulation and characterization. J Drug Deliv Sci Technol. 2020 Feb 1;55. doi: 10.1016/j.jddst.2019.101302, PMID 101302.
Kreuter J. Nanoparticle-based dmg delivery systems. J Control Release. 1991 Jun 1;16(1-2):169-76. doi: 10.1016/0168-3659(91)90040-K.
Khasraghi AH, Thomas LM. Preparation and evaluation of lornoxicam film-forming gel. Drug Invent Today. 2019 Aug 1;11(8).
Tran TTD, Tran PHL. Controlled release film-forming systems in drug delivery: the potential for efficient drug delivery. Pharmaceutics. 2019 Jun;11(6):290. doi: 10.3390/pharmaceutics11060290, PMID 31226748.
Wadile KA, Ige PP, Sonawane RO. Preparation of itraconazole nanoparticles and its topical nanogel: physicochemical properties and stability studies. Int J Pharm Sci Dev Res. 2019 Jan 3;5(1):1-8.
Saudagar RB, Gangurde PA. Formulation, development and evaluation of film-forming gel for prolonged dermal delivery of miconazole nitrate. Res J Top Cosmet Sci. 2017;8(1):19-29. doi: 10.5958/2321-5844.2017.00003.6.
Ngo HV, Tran PHL, Lee BJ, Tran TTD. Development of film-forming gel containing nanoparticles for transdermal drug delivery. Nanotechnology. 2019 Jul 25;30(41):415102. doi: 10.1088/1361-6528/ab2e29.
Hina KS, Kshirsagar RV, Patil SG. Mathematical models for drug release characterization: a review. World J Pharm Pharm Sci. 2015;4(4):324-38.
Ramteke KH, Dighe PA, Kharat AR, Patil SV. Mathematical models of drug dissolution: a review. Scholars Acad J Pharm. 2014;3(5):388-96.
Wang YB, Lian ZX, Chen MN, Zhang L, Zhou CY, Wei W. Bioadhesive drug delivery system of diltiazem hydrochloride for improved bioavailability in cardiac therapy. Trop J Pharm Res. 2016;15(7):1375-80. doi: 10.4314/tjpr.v15i7.4.